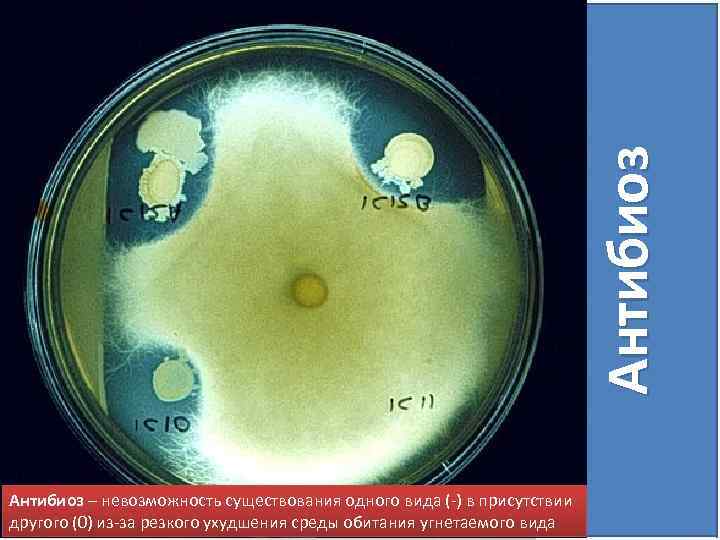

для самостоятельной работы Биотические связи_2017.pptx
- Количество слайдов: 61

БИОТИЧЕСКИЕ CВЯЗИ

Биотические связи (от греч. Biotikos — жизненный) взаимоотношения между различными организмами.

Биотические связи Беклемишев В. Н. разделил биотические связи на 4 группы Топические Трофические Фабрические Форические

ТОПИЧЕСКИЕ СВЯЗИ (от греч. topos — место) формы связи между популяциями в биоценозе, когда особи популяции одного вида видоизменяют физико-химические условия существования другого Крот роет землю меняя среду обитания Бобры строят плотины меняя гидрологический режим

ТРОФИЧЕСКИЕ СВЯЗИ (от греч. trophe - питание) форма связей между популяциями в биоценозе, проявляющихся в питании особей одного вида за счет: • живых особей другого вида, • продуктов жизнедеятельности особей другого вида, • мертвых остатков особей другого вида

ФАБРИЧЕСКИЕ СВЯЗИ (от лат. fabrica - мастерская) такой тип биоценотических отношений, в которые вступает вид, используя для своих сооружений (фабрикации) • продукты выделения особей другого вида • мертвые остатки особей другого вида • или даже живых особей другого вида

ФОРИЧЕСКИЕ СВЯЗИ (от греч. phorá — ношение, несение) межпопуляционных связей, возникающих при транспортировке одних организмов (или органов) другими Рак переносит актинию Семена репейника переносятся животными (зоохория)

Различают прямые и косвенные взаимоотношения между организмами: Гомотопические реакции взаимодействие между особями одного вида Гетеротипические реакции взаимодействие между особями разных видов

Гетеротипические реакции Это взаимодействия между особями, принадлежащими к разным видам. Две популяции либо влияют, либо не влияют друг на друга. (0) – влияние отсутствует (+) – положительное влияние (-) – отрицательное влияние

Гетеротипические реакции НЕЙТРАЛИЗМ СИМБИОЗ ХИЩНИЧЕСТВО АНТИБИОЗ

Нейтрализм (лат. нейтралис - не принадлежащий ни тому, ни другому) оба вида независимы и не оказывают друг на друга никакого влияния. Причина нейтрализма в разных экологических нишах. Широко распространен в природе.

0 0 0

Симбиоз (от греч. symbiosis - сожительство) совместное существование организмов (симбионтов) двух или более видов. Носит чрезвычайно разнообразный характер • Мутуализм • Протокооперация • Комменсализм • Паразитизм

Мутуализм (лат. мутуус – взаимный) 1) форма симбиоза, при которой оба партнера получают пользу, причем относительно равную; 2) форма совместного сосуществования организмов, когда оба партнера или один из них не могут жить без другого

1) Лоцман (+) актиния (+) м у т у а л и з м

2) Клубеньковые микроорганизмы (+) Растение (+) м у т у а л и з м

Мутуализм 2) книжка кишечник пищевод рубец сычуг Жвачное животное (+) микроорганизмы рубца (+) сетка

Сотрудничество (протокооперация) (от лат. cooperatio — сотрудничество) тип взаимоотношений между двумя организмами (популяциями), при котором оба получают пользу, но который не является обязательным и взаимосвязь просто случайна

совместное гнездование нескольких видов птиц позволяет им более успешно защищаться от хищников (++)

Береговые ласточки (+) воробьи (+)

Опылители (+) цветы (+)

Муравьи(+) тли (+)

Комменсализм (франц. комменсал – сотрапезник) такой тип взаимоотношений один вид сообщества – комменсал извлекает пользу от сожительства (+) – хозяин не имеет никакой выгоды (0) Различают • Квартиранство • Сотрапезничество • Нахлебничество • Зоохория

Комменсализм Квартирантство (синойкия) Тип взаимоотношений, при котором один организм использует другого (или его жилище) в качестве места проживания, не причиняя последнему вреда

Квартиранство (синойкия) Растения-эпифиты дерево (0) эпифит (+)

Сотрапезничество — оба вида потребляют разные вещества или части одной и той же пищи Минеральные вещества Дождевой червь Растение Целлюлозолитические грибки

Виды комменсализма – нахлебничество один организм питается остатками пищи другого Нахлебничество Лев (0) Комсенсалы – Шакал, Гриф (+)

Зоохория (греч. зоон – животное, хорео – двигаться) животные способствуют растениям в распространении семян и плодов на шерсти (эктозоохория) и при поедании (эндозоохории)

Паразитизм (гр. празитос – нахлебник) форма взаимоотношений между организмами разных видов, из которых один (паразит) использует другого (хозяина) в качестве среды обитания и источника пищи, возлагая при этом на хозяина регуляцию своих отношений с внешней средой

Паразитов делят на две группы • Микропаразиты – вирусы, бактерии, простейшие • Макропаразиты – круглые и ленточные черви, вши, блохи, клещи и грибы и т. д.

Паразитизм Хозяин (-) паразит (+)

тли гельминты клещ Salmonella Паразитизм

Раффлезия— род цветковых паразитических растений У раффлезии отсутствуют органы, в которых бы шёл процесс фотосинтеза, т. е. отсутствуют и стебли, и листья. Все вещества, необходимые для своего развития, раффлезия получает из тканей (корней или стеблей) растения-хозяина через корни-присоски.

Миноги – вид паразит

Социальные паразиты

Принцип совпадения Чтобы паразит мог развиваться, необходимо совпадение времени поражаемой стадии хозяина и агрессивной стадии паразита. (Таленхорост, 1950)

Чем отличается развитие системы «паразит-хозяин» в агросистеме и естественном ландшафте? Биологическое равновесие в системе паразит – хозяин необходимое условие длительного, теоретически вечного существования биоценозов и сохранения видового разнообразия.

вы зы ва ет Человек, создавая агроценозы 1. Разрушает естественные сообщества 2. Повышает пищевую ценность культурных растений 3. Высевает растения одного сорта Нарушение экологического равновесия, приводящие к гибели хозяина

Хищничество трофические отношения между организмами, при которых один из них (хищник) атакует другого (жертву) и питается частями его тела, то есть обычно присутствует акт умерщвления жертвы Хищник (+) жертва (-)

Убивая и поедая жертв, хищники сокращают численность популяций видов-жертв. Большей частью хищникам удаётся поймать ослабленных (больных), очень молодых или старых животных, не принимающих участия в размножении.

1. Закон периодического цикла процесс уничтожения жертвы хищником нередко приводит к периодическим колебаниям численности популяций обоих видов

В 20 -е гг. А. Лотка и В. Вольтерра независимо друг от друга предложили систему дифференциальных уравнений для описания отношений между хищником и жертвой Закон периодического цикла

2. Закон сохранения средних величин средняя численность популяции для каждого вида постоянна 3. Закон нарушения средних величин при уничтожении популяций обоих видов пропорционально их численности, средняя численность популяции жертвы растет, а популяции хищников падает

Антибиоз (др. -греч. ἀντι- — против, βίος — жизнь) антагонистические отношения видов, когда один организм ограничивает возможности другого, создавая невозможность сосуществования организмов. Различают: • Конкуренция • Аменсализм • Аллелопатия
Антибиоз – невозможность существования одного вида (-) в присутствии другого (0) из-за резкого ухудшения среды обитания угнетаемого вида

Межвидовая конкуренция (от лат. concurro - сталкиваться) это любое антагонистическое отношение, связанное с борьбой за существование, за доминирование, за пищу, пространство и другие ресурсы между популяциями с одинаковыми потребностями, занимающими одну экологическую нишу. + – Европейская норка Американская норка

Правило конкурентного исключения Г. Ф. Гаузе Если два вида с одинаковыми экологическим потребностями оказываются в одном сообществе, то обязательно один конкурент вытесняет другого

Аменсализм (от греч. а — отрицат. частица и лат, mensa — стол, трапеза) форма взаимодействия между популяциями, при котором одна из них подавляет другую без извлечения пользы для себя и без обратного отрицательного воздействия со стороны подавляемой (0) (-)

Светолюбивые травы, растущие под елью, страдают от сильного затемнения, в то время как сами на дерево не влияют.

Аллелопатия (от др. -греч. allelon — взаимно и pathos — страдание) свойство одних организмов выделять химические соединения, которые тормозят или подавляют развитие других. Также иногда под аллелопатией понимают как отрицательные, так и положительные взаимодействия между растениями в фитоценозах. (+) (-) или (+)

Аллелопатия Малина (0) Облепиха (-)

белая акация сирень обладают способностью подавлять рост соседних растений калина барбарис

Гомотопические реакции - взаимодействие между особями одного вида Групповой эффект Все изменения, происходящие с особями одного вида, связанные с объединением их в группы по две и более особей Происходит оптимизация физиологических процессов, ведущая к повышению жизнеспособности при совместном существовании Следствие: - значительное ускорение роста

пчелы в группе способны в улье поддерживать постоянную температуру

один из видов бакланов не может существовать только в колониях, насчитывающих не менее 10 тыс. особей

слоны живут и размножаются в стаде не менее чем из 25 животных

Принцип «минимального размера популяции» она не может состоять из меньшего числа индивидов, чем необходимо для обеспечения стабильности и устойчивости популяции

Гомотопические реакции Массовый эффекты, связанные с перенаселением Массовый эффект влечет за собой, как правило, вредные для животных последствия.

Гомотопические реакции Внутривидовая конкуренция взаимоотношения между организмами одного и того же вида, соревнующимися за одни и те же ресурсы окружающей среды при их недостатке

Гомотопические реакции – Внутривидовая конкуренция в территориальном поведении, когда животное защищает место своего гнездовья в социальной иерархии конкуренция из-за ресурса, например и-за пищи

Таким образом, биотические отношения являются • одним из важнейших механизмов формирования видового состава сообществ, • пространственного распределения видов, • регуляции их численности, • имеют значение для процесса эволюции.
для самостоятельной работы Биотические связи_2017.pptx